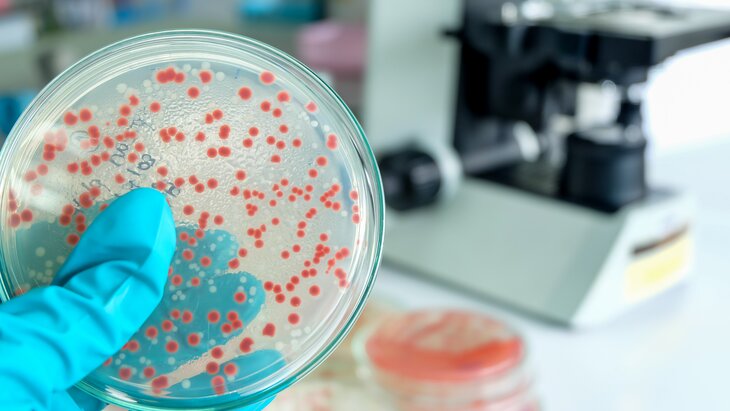

12 августа 2025, 13:14
ДиагнозыДачные участки таят в себе множество опасностей и рисков для здоровья. Какие недуги подстерегают любителей провести время вдалеке от города и как защитить свой организм – расскажем в нашем материале.
Инфекционные заболевания

Фото: 123RF/zinkevych
Наиболее распространенными патологиями среди дачников считаются болезни инфекционной природы, рассказала врач Вера Сережина в беседе с РИАМО.
По словам специалиста, геморрагическая лихорадка с почечным синдромом (ГЛПС), или мышиная болезнь, вызываемая бактериями иерсиниями, возглавляет список самых опасных дачных заболеваний. При этом вероятность распространения возбудителя инфекции повышается, если грызуны проживали на участке в зимний период.
Кроме того, возрастает риск заражения грибками, поскольку вирусные микроорганизмы окружают человека повсеместно: в почве, воздухе, на растениях и различных поверхностях. К примеру, патогены могут проникать в организм через микротрещины на руках и ногах во время проведения дачных работ.
Также эксперт предупредила о высоком риске заболеть кишечными инфекциями, особенно если дачники используют для полива жидкость из водоемов, где обитают водоплавающие птицы. Лебеди, утки и гуси могут быть переносчиками бактерий, вызывающих холеру, дизентерию и сальмонеллез.
Помимо птиц, угрозу здоровью представляют крысы и ежи, поскольку они являются потенциальными переносчиками бешенства от диких животных. При этом острой вирусной болезнью могут заразиться и домашние питомцы, особенно если они ловят грызунов.
Эхинококкоз
Фото: 123RF/tinydevil
Достаточно редким, но не менее опасным недугом для дачников считается эхинококкоз – тяжелое паразитарное заболевание, вызываемое личиночными формами ленточных червей. Об этом сообщил изданию 360 врач-педиатр Морозовской больницы, доцент кафедры детских болезней Сеченовского университета Павел Бережанский.
Эхинококкозом можно заразиться через воду, набранную из речки или водоема, почву или непрожаренное козье и коровье мясо. Личинка проникает в организм вместе с капсулой, которая растворяется под действием желудочно-кишечного сока, после чего образуется взрослая особь.
Чаще всего паразит обитает в печени, легких, головном мозге и сердечной мышце. При попадании в органы дыхательной системы микроорганизм провоцирует кровохарканье и неприятные ощущения в груди, особенно при дыхании. Если же личинка поселилась в сердце, то это может стать причиной летального исхода.
Соматические болезни

Фото: 123RF/tidty
Зачастую дачниками являются люди пожилого возраста, у которых могут быть диагностированы заболевания сердечно-сосудистой системы, подчеркнула Сережина. При сильной физической нагрузке соматические патологии обостряются, вызывая повышенное артериальное давление и в некоторых случаях сердечной приступ.
Во время работы на садовом участке в жару есть риск получения солнечного или теплового удара. Для предотвращения проблем с сердцем и перегревом организма рекомендуется всегда иметь при себе нитроглицерин и препараты от гипертонии, носить головные уборы, надевать легкую светлую одежду с длинными рукавами и соблюдать питьевой режим.
Кроме того, в дачной аптечке должны быть средства для оказания первой помощи при глубоких порезах, в частности для остановки кровотечения. Проведение первичной хирургической обработки ран перекисью водорода, йодом и стерильными салфетками позволит снизить риск заражения анаэробными инфекциями, такими как столбняк и газовая гангрена.
Ранее психолог рассказала, что дачные работы помогают бороться с нервным напряжением.
 Корегин Владислав
Корегин Владислав



















